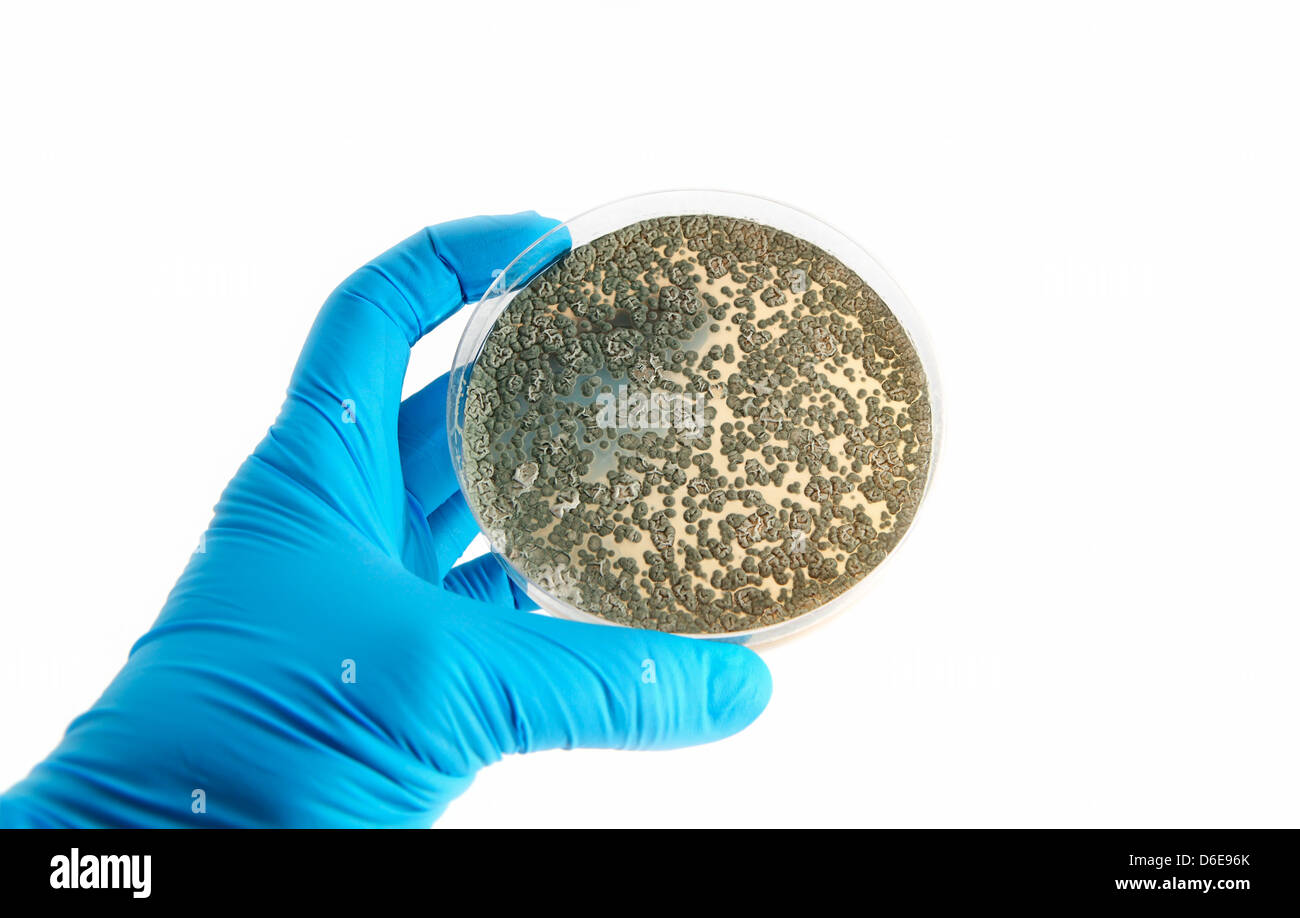
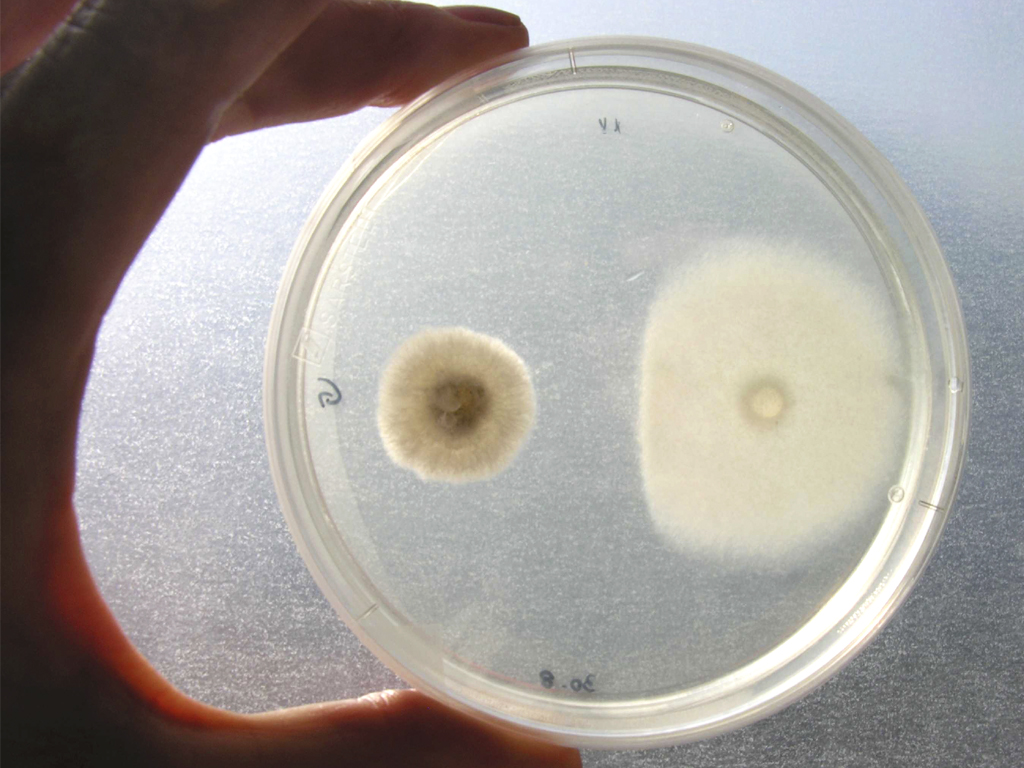

Piastra Laboratorio
BuoQua 12x12cm Agitatore Magnetico Riscaldante Con La Piastra SH2 Laboratorio Agitatore Magnetico Macchina Per Mescolare 1L Riscaldante 380°C Massimo Miscelatore Da Laboratorio Magnetico 4,3 su 5 stelle 13 84,44 €.

Piastra laboratorio. Originally from Boston, Piastra’s Chef Owner Greg learned about food at a young age when he first learned the phrase, “Food is love” His first culinary steps were what captured his passion Grandmother Rose showed him how to make chocolate chip cookies, and he states that he is still perfecting the recipe. In laboratorio di chimica si usano generalmente i seguenti mezzi riscaldanti il bunsen (ossia la sua fiamma diretta), la piastra elettrica, il bagnomaria e la stufa La scelta del mezzo dipende dalla temperatura che si vuole raggiungere, dalle condizioni di sicurezza da osservare e dalla velocità del riscaldamento Il bunsen. In laboratorio di chimica si usano generalmente i seguenti mezzi riscaldanti il bunsen (ossia la sua fiamma diretta), la piastra elettrica, il bagnomaria e la stufa La scelta del mezzo dipende dalla temperatura che si vuole raggiungere, dalle condizioni di sicurezza da osservare e dalla velocità del riscaldamento Il bunsen.
PIASTRA MILLEFORI PIAZZOLA 3 FORI Piastra millefori professionale con piazzola a tre fori SPECIFICHE Circuito stampato millefori a singola faccia in resina epossidica FR4, spessore 1,6 mm, lamina di. In questo periodo di festa ma anche di bilanci, di nuovi progetti e sfide per il nuovo anno, vogliamo. Nel Laboratorio di Chimica i rischi e i pericoli possono essere chimici quelli che coinvolgono i prodotti chimici (ustioni, irritazioni, sensibilizzazioni da contatto);.
PiAstra is a system for pasteurizing Human Breast Milk, which has proven to be the ideal source of optimal nutrition for all infants For low birth weight infants especially, it is like personalised medication as these infants are at great risk of developing necrotising enterocolitis, a very serious condition of the gut if they don’t get breastmilk. Rovesciare la piastra e incubare in termostato a 36°C per 48 ore SEMINA inclinato) vengono utilizzate in laboratorio per il mantenimento e la conservazione dei batteri aerobi che, se collocati in ambiente refrigerato e in provetta sempre mantenuta sterile, sono in grado di sopravvivere. Agitatore magnetico riscaldato da laboratorio Heidolph Serie MR con piastra riscaldante in KERADISK per una perfetta distribuzione della temperatura, e un potente motore Ermetico per agitare fino a litri di acqua, e fino a 1400 giri/min L’agitatore magnetico ha la regolazione digitale della temperatura fino a 300 °C, con una notevole potenza disponibile di 800 W per veloci tempi di raggiungimento della temperatura e risparmio energetico.
Il Sito Italiano N1 per i Laboratori per acquistare Apparecchiature, Consumabili, Cappe,Piastre,Bilance,Strumenti,Incubatori,Stufe, Strumenti,Autoclavi,Vetreria, Reagenti ed altro!. Padiglione 15 Piastra dei Servizi, piano terra Il padiglione apre al pubblico alle ore 0645, le attività di prelievo iniziano alle ore 0715 Il Centro Prelievi effettua prelievi ematici a persone al di sopra dei 12 anni ;. LABORATORIO E SUI POLPASTRELLI DELLE DITA DELLE MANI Colonie di batteri in piastra di Petri OBBIETTIVO Osservare al microscopio ottico le cellule batteriche, descriverne le caratteristiche valutandone le dimensioni, la forma , margine e profilo.
Info sanitarie su diagnostica di laboratorio Di persona al totem del Padiglione 15 Piastra dei Servizi, Sala di ingresso, tasto "INFO SANITARIA PRELIEVI" dal lunedì al venerdì ore 1000 – 1600, sabato ore 1000 1230 Tel 055 794 9464 dal lunedì al sabato ore 1000 10 risponde su interpretazione delle richieste di esami. In laboratorio di chimica si usano generalmente i seguenti mezzi riscaldanti il bunsen (ossia la sua fiamma diretta), la piastra elettrica, il bagnomaria e la stufa La scelta del mezzo dipende dalla temperatura che si vuole raggiungere, dalle condizioni di sicurezza da osservare e dalla velocità del riscaldamento Il bunsen. La prova di carico su piastra eseguita secondo la normativa BU CNR 146/92 determina il modulo di deformazione Md, che rappresenta una misura convenzionale della capacità portante dei terreni di sottofondo, degli strati di rilevato nonché degli strati non legati di fondazione e di base delle pavimentazioniEsso viene determinato a mezzo di una prova di carico con piastra circolare ed è.
I mantelli riscaldanti, come le piastre riscaldanti con bagni riscaldanti, sono spesso usati in laboratorio per riscaldare palloni per operazioni di distillazione o per lo svolgimento di reazioni chimiche In particolare, tale dispositivo viene utilizzato per lo sviluppo di reazioni endotermiche che richiedano per potere avere luogo temperature superiori a 100 °C, ovvero superiori alla. I soggetti di età inferiore possono rivolgersi alla Azienda Ospedaliero Universitaria Meyer. Gli Ambulatori per le visite specialistiche, i controlli e le medicazioni sono al secondo piano dell'Ospedale Giustinianeo, di fronte al Policlinico Universitario (sempre all'interno dell'area dell'Azienda Ospedaliera di Padova Tel CUP 840 000 664) L'attività di Endoscopia (Esofagogastroscopia) si svolge presso la Piastra Endoscopica Ospedale Giustinianeo 2° piano (sempre all'interno dell.
Piastra laboratorio patogeno piastra laboratorio patogeno Newsletter Scopri un servizio d'informazione di alta qualità liato sulle tue esigenze Iscriviti EDIZIONI L'INFORMATORE AGRARIO Srl Via BencivengaBiondiani, 16 Verona I SEDE Tel info@informatoreagrarioit. Piastra Laboratorio Handling Systems Quota mercato 21, dimensioni tendenze chiave globali, domanda del settore, risultati chiave, analisi regionale, profili dei principali attori, prospettive future e previsioni fino al 26. Piastra Pronta Petri da 90 mm Tryptic Soy Agar con LTH (TSALTH) Recommended by the Harmonised European Pharmacopoeia, supplemented with Lecithin, Polysorbate 80 (Tween 80) and LHistidine prerequisito essenziale per le attività di un Laboratorio che esegue analisi microbiologiche.
Non Perdere Più Tempo, Acquista e Ricevi in 3 Click. / Laboratorio / Piastre calde / IKA / Piastra riscaldante IKA CMAG HP 10 IKATHERM® IKA CMAG HP 10 Piastra riscaldante IKA CMAG HP 10 IKATHERM® IKA CMAG HP 10 4 stars Consulenza certificata Cliente Ottimo servizio clienti e risposte rapide a tutte le domande. Termostatico Laboratorio Piastra Calda/Laboratorio Agitatore Magnetico piastra Calda >> Introduzione di prodotto.
Scopri tutte le informazioni sul prodotto piastra riscaldante da laboratorio dellazienda VAGUES SERVICES Contatta il fornitore o un suo rivenditore per chiedere il prezzo di un prodotto, ottenere un preventivo o scoprire i punti vendita più vicini. Piastra riscaldante da laboratorio All'interno dei laboratori le piastre riscaldanti sono uno degli strumenti base, indispensabili per scaldare determinate sostanze, generalmente l'acqua e l'olio. La prova di carico su piastra eseguita secondo la normativa BU CNR 146/92 determina il modulo di deformazione Md, che rappresenta una misura convenzionale della capacità portante dei terreni di sottofondo, degli strati di rilevato nonché degli strati non legati di fondazione e di base delle pavimentazioniEsso viene determinato a mezzo di una prova di carico con piastra circolare ed è.
41 conta microbica in piastra pag 37 42 conta su terreno liquido pag 40 43 conta per filtrazione su membrana pag 42 4 4 analisi microbiologica dell’acqua potabile pag 46 5 caratteristiche metaboliche dei microrganismi 51 utilizzazione dell’amido pag 61 52 utilizzazione di carboidrati diversi pag 64 53 ossidazione e fermentazione. Piastra Riscaldante Le piastre riscaldanti sono appositamente studiate per soddisfare le comuni esigenze di laboratorio e per tutte quelle applicazioni che richiedono il riscaldamento di sostanze liquide contenute all’interno di opportuni contenitori. Piastra da essiccatore infrangibile, levigata a fuoco, resistente alla corrosione, inerte, con superficie in vetro antiaderente incollata al metallo Adatta per gli essiccatori , e.
Laboratorio prove materiali autorizzato dal Ministero Infrastrutture Trasporti art 59 del DPR 380/01 e art legge 1086/71 (n° del 17/12/1993 e succ rinnovi) Laboratorio geotecnico autorizzato dal Ministero Infrastrutture Trasporti art 59 del DPR n° 380/01 (n° del 14/07/05 e succ rinnovi) Sistema qualità certificato. Scopri tutte le informazioni sul prodotto piastra riscaldante digitale Cimarec™ Basic dellazienda Thermo Scientific Contatta il fornitore o un suo rivenditore per chiedere il prezzo di un prodotto, ottenere un preventivo o scoprire i punti vendita più vicini. Le migliori offerte per Corning PC35 Caldo Piastra Stimolatore Laboratorio Piastra Riscaldante sono su eBay Confronta prezzi e caratteristiche di prodotti nuovi e usati Molti articoli con consegna gratis!.
Scopri tutte le informazioni sul prodotto piastra Petri dellazienda Sarstedt Contatta il fornitore o un suo rivenditore per chiedere il prezzo di un prodotto, ottenere un preventivo o scoprire i punti vendita più vicini. Piastra riscaldante da laboratorio capace di portare la temperatura fino a 70° grazie al termostato integrato Facile consultazione grazie ad display digitale e manopola di regolazione Dimensioni 26xcm, altezza 8cm, peso 4kg. L’analisi ELISA è ormai fortemente consolidata tra le tecniche di laboratorio ma non è certo infallibile Il vantaggio principale è l’alta sensibilità e specificità diagnostica può essere usata per quantificare molecole contenute in vari campioni, compresi siero, plasma, urina, saliva o estratti di tessuto.
La piastra è provvista di un coperchio che permette il passaggio di aria, necessaria nella maggior parte dei casi per la crescita batterica, e impedisce il passaggio di altri microorganismi che potrebbero contaminare il terreno. Laboratorio di torino 24/12 chiusi tutto il giorno 2930/12 aperti solo al mattino dal 31/12 al 10/01 chiusi tutto il giorno l'apertura al pubblico ripartira' da lunedi' 11 gennaio. Contattaci allo o scrivici a mpim@mpimit Buone Feste!.
LABORATORIO E SUI POLPASTRELLI DELLE DITA DELLE MANI Colonie di batteri in piastra di Petri OBBIETTIVO Osservare al microscopio ottico le cellule batteriche, descriverne le caratteristiche valutandone le dimensioni, la forma , margine e profilo. Laboratorio Geotecnico (Laboratorio autorizzato DPR 380/01 art 59) attrezzato per tutte le prove sulle terre classificazione, prova edometrica, prova di taglio diretto, prove triassiali, prova di permeabilità, di compattazione, CBR, ecc Prove di piastra su piani di fondazione, rilevati e sottofondi di pavimentazioni Prove di densità. Zetalab srl Via Umberto Giordano, 5 Padova Italy Tel 049/ Fax 049/ Partita IVA.
LABORATORIO GEOTECNICO VIVIRITO Via Edison, 142/aTel/Fax CAMPOBELLO DI LICATA (AGRIGENTO) Decreto conc/05 per esecuzione e certificazione prove di laboratorio sui terreni. Bar dwg, Bar caffetteria dwg, progetto di un bar, caffetteria dwg, progetto bar autocad, progetto piccolo bar, wine bar dwg, american bar dwg, lounge bar dwg, download gratuito, vasta scelta di file dwg per tutte le necessità del progettista, profili bar, macchina caffè dwg, bancone bar dwg, bancone bar, download dwg, dwg gratis, moduli work station, moduli coktail, cocktails stations. Agitatore magnetico riscaldato da laboratorio Heidolph Serie MR con piastra riscaldante in KERADISK per una perfetta distribuzione della temperatura, e un potente motore Ermetico per agitare fino a litri di acqua, e fino a 1400 giri/min L’agitatore magnetico ha la regolazione digitale della temperatura fino a 300 °C, con una notevole potenza disponibile di 800 W per veloci tempi di raggiungimento della temperatura e risparmio energetico.
Pezzi Plastica di Petri con Coperchio,MONOUSO Piastra di Petri Sterilizzata Trasparente, per Cultura di Laboratorio Lievito Batterico(90mm) con pipette di trasferimento in plastica da 5 ml. Qualità delle prestazioni di laboratorio I campioni biologici sono identificati con un codice a barre che ne consente la tracciabilità in tutte le fasi del processo dalla richiesta (differenziata secondo le modalità di accesso degli utenti), al prelievo, all’esecuzione della metodica analitica fino all’archiviazione del referto. L’analisi ELISA è ormai fortemente consolidata tra le tecniche di laboratorio ma non è certo infallibile Il vantaggio principale è l’alta sensibilità e specificità diagnostica può essere usata per quantificare molecole contenute in vari campioni, compresi siero, plasma, urina, saliva o estratti di tessuto.
Piastra riscaldante La piastra riscaldante è un agitatore magnetico che permette anche il riscaldamento del miscuglio Il suo piatto di supporto è infatti dotato di una resistenza elettrica Piastra riscaldante La temperatura del riscaldamento e la velocità di rotazione dell'ancoretta sono regolate da due manopole indipendenti tra loro. Il Sito Italiano N1 per i Laboratori per acquistare Apparecchiature, Consumabili, Cappe,Piastre,Bilance,Strumenti,Incubatori,Stufe, Strumenti,Autoclavi,Vetreria, Reagenti ed altro!. L’analisi ELISA è ormai fortemente consolidata tra le tecniche di laboratorio ma non è certo infallibile Il vantaggio principale è l’alta sensibilità e specificità diagnostica può essere usata per quantificare molecole contenute in vari campioni, compresi siero, plasma, urina, saliva o estratti di tessuto.
Non Perdere Più Tempo, Acquista e Ricevi in 3 Click. View Menu find us Rocky Hill. Video tratto da Valitutti Dal carbonio agli OGM, Zanichelli editore SpA, 14http//onlinescuolazanichelliit/dalcarbonioagliogm/.
Laboratorio di torino 24/12 chiusi tutto il giorno 2930/12 aperti solo al mattino dal 31/12 al 10/01 chiusi tutto il giorno l'apertura al pubblico ripartira' da lunedi' 11 gennaio. GRAZIE a tutti voi!. Piastra riscaldante La piastra riscaldante è un agitatore magnetico che permette anche il riscaldamento del miscuglio Il suo piatto di supporto è infatti dotato di una resistenza elettrica Piastra riscaldante La temperatura del riscaldamento e la velocità di rotazione dell'ancoretta sono regolate da due manopole indipendenti tra loro.
Piastra da laboratorio Ordinare per FILTRARE PER Set 10 Misurino Caraffa Graduata Contenitore Graduato Laboratorio Plastica Becher 500ml Consegna gratuita Scopri le caratteristiche tecniche Aggiungi al carrello 41. PIASTRA MILLEFORI PIAZZOLA 3 FORI Piastra millefori professionale con piazzola a tre fori SPECIFICHE Circuito stampato millefori a singola faccia in resina epossidica FR4, spessore 1,6 mm, lamina di. Vi sono 4955 laboratorio piastra calda fornitori, principalmente situati in AsiaI principali paesi o regioni fornitori sono La Cina, Il Giappone, eL'India, che forniscono rispettivamente il 98%, 1%, e1% di laboratorio piastra calda.
Le pratiche di laboratorio in uso nelle nostre scuole con standard europei Con si è voluto soprattutto costruire una dotazione sperimentale collaudata e di facile realizzazione, che possa diventare nel tempo largamente utilizzata, così da costituire un patrimonio condiviso che permetta la. La Piastra Gourmet To Go & Catering is the perfect solution, offering a wide variety of takeout options that are fresh and ready to heat and serve, plus full catering options for your special events See the delicious specials we're cooking up this month!. Fisici provocati da fonti di calore o dalla corrente elettrica;.
I mantelli riscaldanti, come le piastre riscaldanti con bagni riscaldanti, sono spesso usati in laboratorio per riscaldare palloni per operazioni di distillazione o per lo svolgimento di reazioni chimiche In particolare, tale dispositivo viene utilizzato per lo sviluppo di reazioni endotermiche che richiedano per potere avere luogo temperature superiori a 100 °C, ovvero superiori alla. Piastra riscaldante La piastra riscaldante è un agitatore magnetico che permette anche il riscaldamento del miscuglio Il suo piatto di supporto è infatti dotato di una resistenza elettrica Piastra riscaldante La temperatura del riscaldamento e la velocità di rotazione dell'ancoretta sono regolate da due manopole indipendenti tra loro. Pesare in laboratorio Bilance affidabili, precise e dalle alte performance La scelta giusta Supporto e consulenza specialistica Come possiamo aiutarti?.
Scarica questo Foto premium su Piastra di petri laboratorio microbiologico colture di muffe e funghi e scopri oltre 7 milioni di foto d'archivio professionali su Freepik. IN STOCK Piastra Mica Forni a Microonde SAMSUNG al miglior prezzo Consegna rapida e spedizione in tutta Italia Un'ampia scelta tra 0 Pezzi di ricambio per forno, stufa, cucina (a gas, elettrica). Scopri la nostra gamma di piastre riscaldanti e agitatori con piastra riscaldante Qualità eccezionale, dagli agitatori di base agli agitatori con piastre riscaldanti a prova di esplosione per soddisfare tutte le esigente del tuo laboratorio.
Per questo vogliamo che i nostri agitatori diventino per il vostro laboratorio compagni fedeli a affidabili nel tempo M2A, M2D Pro e M3D agitatori magnetici con riscaldamento, dalle dimensioni e fattezze diverse della piastra, fino alla possibilità di inserire una sonda di temperatura PT1000 esterna.

Coltura Di Batteri Su Piastra Di Agar Scena Laboratorio Fotografie Stock Freeimages Com

Piastra Riscaldante Digitale Gh Series Biobase Per Liquidi Di Laboratorio

Agitatore Magnetico Con Piastra Riscaldante 550 C Agitatori Con Piastra Riscaldante Piccola Strumentazione Biosigma Materiale Per Laboratorio
Piastra Laboratorio のギャラリー

Il Microbiologo Sta Facendo Cadere Un Test Sulla Piastra Di Coltura Dei Media In Laboratorio Immagine Stock Immagine Di Mano Diagnosi

Ohaus Presenta I Nuovi Agitatori Magnetici Con Piastra Riscaldante

Agitatore Magnetico Piastra Riscaldante Miscelatore Laboratorio 660 Watt Pid Ebay

Piastra Riscaldante In Vetroceramica Pv300 Zetalab

Piastra Riscaldante 1500 W Ml Systems

Zhongxing Laboratorio Agitatore Magnetico Con Piastra Riscaldante 79 1 85 2 Zxc 2 Buy Agitatore Magnetico Con Piastra Riscaldante In Ceramica Di Buona Qualita Laboratorio Digitale Agitatore Magnetico Temperatura Regolabile Agitatore Magnetico Con

Agitatore Di Laboratorio Con Piastra Riscaldante Agitatore Di Laboratorio Riscaldante Tutti I Produttori Di Materiale Medicale Video

Buoqua 12x12cm Agitatore Magnetico Riscaldante Con La Piastra Sh 2 Laboratorio Agitatore Magnetico Macchina Per Mescolare 1l Riscaldante 380 C Massimo Miscelatore Da Laboratorio Magnetico Amazon It Fai Da Te

Vevor Agitatore Magnetico Sh 2 Agitatore Magnetico Da Laboratorio Piastra Riscaldante 00 Ml Capacita Di Miscelazione Con Piastra Riscaldante Miscelatore Riscaldante Display Digitale Amazon It Commercio Industria E Scienza
Piastra Di Agar Con Funghi In Crescita Di Microrganismi In Laboratorio Foto Stock Alamy

Sh 2 Laboratorio Miscelatore Magnetico Agitatore Piastra Calda A Doppio Controllo Con Barre Magnetiche Di Agitazione Amazon It Commercio Industria E Scienza

6150 Piastra Riscaldante In Ghisa Con Regolazione Elettronica Optikascience

Twjr B Serie Strumento Di Laboratorio Elettrico Piastra Di Riscaldamento Agitatore Magnetico Buy Piastra Di Riscaldamento Elettrico Piastra Calda Agitatore Magnetico Piastra Calda Product On Alibaba Com

Agitatore Magnetico Piastra Riscaldante Miscelatore Mixer Laboratorio 310 Watt Ebay

Piastra Riscaldante Digitale Da Laboratorio H329 17
Piastra Laboratorio Patogeno L Informatore Agrario

Piastra Da Stiro X Tessuti Da Laboratorio Firenze Toscana

Agitatore Magnetico Con Piastra Riscaldante Argolab Ebay

Piastra Di Petri Laboratorio Microbiologico Colture Di Muffe E Funghi Foto Premium

Piastra Petri Con Il Fungo Su Microscopio Da Laboratorio Fungo Carta Da Parati Carte Da Parati Batteriologia Che Fungine Myloview It

Microrganismi Dei Funghi Sulla Piastra Di Agar In Laboratorio Fotografia Stock Immagine Di Macro Piatto

Termoshaker A Piastra Biosan Pst 100hl 1 187 50

Zhaodalei Piastra Riscaldante Per Agitatore Magnetico Da Laboratorio Piastra Per Agitazione Miscelatore Magnetico 100 00rpm 180w Potenza Di Riscaldamento 350 C Amazon It Sport E Tempo Libero

Mescolatore Magnetico Della Piastra Riscaldante Fabbrica Comprare Di Buona Qualita Mescolatore Magnetico Della Piastra Riscaldante Prodotti Dalla Cina

Piastra Riscaldante Da Laboratorio Analogica H329 19

Piastra Riscaldante Di Precisione Pz Series Harry Gestigkeit Gmbh Da Laboratorio Digitale Elettrica

Zncl B 230 230 Millimetri Di Laboratorio Intelligente Piastra Di Riscaldamento Piastra Calda Agitatore Magnetico 2v Dispositivi Termostatici Da Laboratorio Aliexpress

Agitatore Magnetico Con Piastra Riscaldante Heidolph Agitador Laboratorio Tipi Di Trombone 510 510 Png Trasparente Scarica Gratis Scala Di Peso Hardware Giradischi

Agitatore Con Piastra In Vetroceramica M3 D Zetalab

Piastra Di Petri Laboratorio Microbiologico Colture Di Muffe E Funghi Foto Premium

Acquista Agitatore Magnetico Da Laboratorio Sh 3 Con Piastra Riscaldante Piastra Riscaldante Miscelatore Magnetico Pannello In Alluminio 0 1600 Giri Min Volume 5000 Ml A 145 29 Dal Symeng Dhgate Com

Sh 3 Di Laboratorio Agitatore Magnetico Con Riscaldamento Laboratorio Mescolare Piatto Blender Mixer Piastra Calda Con Ancoretta Magnetica Bar Dispositivi Termostatici Da Laboratorio Aliexpress

A Disposizione Riflettere Yogurt Piastre Riscaldanti Da Laboratorio Amazon Agingtheafricanlion Org

Piastra Riscaldante Hp 7 Ikaterm Laboratorio Shop

Ukcoco Piastra In Coltura Premium In Plastica Piastra In Coltura Cellulare A 24 Pozzetti Per Laboratorio Commercio Industria E Scienza Prodotti Scientifici E Per Laboratorio

Agitatori Di Laboratorio A Piastra Riscaldante Ika Tutti I Prodotti Su Directindustry

Piastra Riscaldante Con Agitatore Magnetico E Piastra Riscaldante Da Laboratorio 100 1600 Giri Min Max 380 C Doppio Controllo Per Riscaldamento A Miscelazione Di Liquidi Da Laboratorio Amazon It Sport E Tempo Libero

Strumenti Da Laboratorio Archives Tqc Italia

Piastra Riscaldante Da Laboratorio
Ohaus Gli Agitatori Con Piastra Riscaldante Guardian Con Funzionalita Smart Garantiscono Sicurezza

Becher Con Acqua Che Riscalda Sulla Piastra Riscaldante Immagine Stock Immagine Di Closeup Metallo

Faithful Miscelatore A Piastra Riscaldante Per Agitatore Magnetico Sh 2 Da Laboratorio Con Barra Magnetica Amazon It Commercio Industria E Scienza

Piastra Di Petri Laboratorio Microbiologico Stampo E Colture Fungine Ricerca Batterica Foto Stock Alamy

Hukoer Macchina Di Agitatore Magnetico A Piastra Calda Miscelatore Da Laboratorio 1000ml 85 2

Liceo Cassini Laboratorio Di Chimica

Milizia Dinamica Leia Miscelatore Da Laboratorio Amazon Agingtheafricanlion Org

Piastra Riscaldante Con Agitatore Ml Systems

Piastra Riscaldante Per Il Laboratorio Chimico E Farmaceutico

Bilancia Da Laboratorio Con Piastra Metallica Scarica Immagini Vettoriali Gratis Grafica Vettoriale E Disegno Modelli

Piastra Riscaldante Ghisa Cir 1 Labware Generic Labware

Piastra Petri Vetro Diametro 15 Cm Laboratorio Pcm 3417 Ebay

Agitatore Magnetico Con Piastra Riscaldante Ceramica Miscelatore Laboratorio Eur 3 00 Picclick It

Piastra Da Riscaldate Da Laboratorio H329 18

A Disposizione Riflettere Yogurt Piastre Riscaldanti Da Laboratorio Amazon Agingtheafricanlion Org

Agitatore Di Laboratorio Magnetico F80 Digit Falc Instruments S R L Digitale Per Becher A Piastra Riscaldante

Cina Agitatori Magnetici Chimici Liquidi Della Piastra Riscaldante Del Laboratorio Acquistare Agitatori Magnetici Sopra It Made In China Com

Il Lavoro Di Laboratorio Preparazione Di Campioni In Un 96 Pozzetti Della Piastra Pcr Nell Elisa Diagnostica Foto Stock Alamy

Agitatore Magnetico Piastra Riscaldante Laboratorio Analisi Miscelatore Mg1 Vendita Online

Attrezzature Di Laboratorio Hms 901d 2 Agitatore Magnetico Con Riscaldamento Stir Bar Piastra Calda Chimica Di Laboratorio Agitatore Magnetico Mixer Materiale Didattico Aliexpress

Agitatore Di Laboratorio Magnetico Ew 01 Stuart Equipment Analogico A Piastra Riscaldante Verticale

Piastra Di Petri Wikipedia

Piastre Di Petri 65 Mm Tipo Contact Asettica Microbiologia Prodotti Da Laboratorio

Agitatore Di Laboratorio Magnetico Arex Velp Scientifica Digitale Da Banco A Piastra Riscaldante

Piastra Riscaldante Laboratorio Produttore E Fornitore Di Taiwan Commercio All Ingrosso Distributori Oem Odm Laboratoryequipment Com Tw

Piastra Riscaldante Applic Alta Precisione Mod Pa Vetroscientifica

Piastra Riscaldante Da Laboratorio

Agitatori Vibranti Heidolph Per Laboratorio E Industria

Piastra Di Petri Laboratorio Microbiologico Colture Di Muffe E Funghi Foto Premium
Sh 2 Laboratorio Miscelatore Magnetico Agitatore Piastra Calda A Doppio Controllo Con Barre Magnetiche Di Agitazione Apparecchi Di Miscelazione Strumenti E Apparecchi Per Laboratorio

Piastre Petri In Polistirene Trasparente Piastre Petri Consumabili Da Laboratorio Biosigma Materiale Per Laboratorio

T2 Hs380 Laboratorio Mixer Piastra Riscaldante Agitatore Magnetico 380c 1500 Ebay

Ika Agitatore Magnetico Con Piastra Riscaldante Con Controllo Di Sicurezza Ika Rct Basic Ikamag 230v 50 60hz Piastre Riscaldanti Con Agitazione Fisher Scientific

Piastra Riscaldante Infrarossi Cr300 Stuart Plaques Agitateurs Chauffants Attrezzatura Biosigma Materiale Per Laboratorio

Agitatore Magnetico

Piastra Riscaldante Analogica Corning Pc 0 Corning Bv Per Liquidi Di Laboratorio

Piastra Riscaldante Bilance Microscopi Piastre Phase Restauro

Acquista Agitatore Magnetico Con Riscaldamento Piastra Piastra Miscelatore Di Laboratorio Agitatore 2v 110v Dual Control Con 1 Pollice Stir Bar C3 A 71 84 Dal Symeng Dhgate Com

Laboratorio Di Microbiologia Di Colture Cellulari Piastre Di Petri Contenenti Le Colture Cellulari Sotto Una Cappa Biologica Foto Stock Alamy

Piastra Di Petri Laboratorio Rm Clip 379 971 271 In Hd Framepool Stock Footage

Cina Piastra Di Riscaldamento Del Riscaldatore Del Laboratorio Di Db Ii Piastra Riscaldante Del Laboratorio Acquistare Piastra Riscaldante Sopra It Made In China Com

Acquista Agitatore Magnetico Da Laboratorio Sh 2 Con Miscelatore Riscaldante Miscelatore A Piastra Riscaldante Da Laboratorio Piastra Riscaldante Con Barra Di Mescolamento Magnetico A 92 38 Dal China Laboratory Dhgate Com

Cina Piastra Riscaldante Di Ceramica Bianca Piastra Riscaldante Di Ceramica Del Laboratorio Per Sh 4a Acquistare Piastra Riscaldante Elettrica Di Ceramica Sopra It Made In China Com

Piastra Riscaldante Digitale J Nhp Jisico Per Liquidi Di Laboratorio

Piastra Petri Con Il Fungo Su Microscopio Da Laboratorio Fungo Carta Da Parati Carte Da Parati Che Petri Analisi Myloview It

Piastre Riscaldate Geass Torino

Piastra Riscaldante Con Agitatore Magnetico Agitatore Da Laboratorio Echipament De Laborator Altri Scaricare Png Disegno Png Trasparente Bilancia Da Cucina Png Scaricare

Piastra Di Petri Da Laboratorio

Piastre Riscaldante Cimarec Plaques Agitateurs Chauffants Attrezzatura Biosigma Materiale Per Laboratorio

Nuovo Laboratorio Riscaldato Piastra Agitatore 0 1600rpm 1l 5l Miscelazione Importo Con Parametro Set Chiave Sensore Sonda Di Temperatura Display A Cristalli Liquidi Di Fissaggio Supporto Per Riscaldamento E Agitazione Liquido Hs 17 3l

Piastra Riscaldante Digitale Da Laboratorio H329 17

Agitatore Magnetico

Piastra Riscaldante In Vetroceramica Pv0 Zetalab

Piastra Riscaldante A Articoli Di Laboratorio E Scienze Mediche Acquisti Online Su Ebay

Piastra Fumo Dentro Microbiologia Cultura Scienziato Cappio Usando Laboratorio Batterico Inoculazione Cappuccio Canstock

Agitatore Di Laboratorio Magnetico F60 Falc Instruments S R L Orizzontale A Piastra Riscaldante Con Regolazione Della Luminosita

Piastra Riscaldante Con Agitatore Magnetico Laboratorio Di Chimica Calore Altri Scaricare Png Disegno Png Trasparente Tecnologia Png Scaricare

85 2 Agitatore Magnetico Con Miscelatore Per Piastra Riscaldante Con Attrezzatura Per Laboratorio Scolastico Piastra Riscaldante Bianco Amazon It Casa E Cucina



